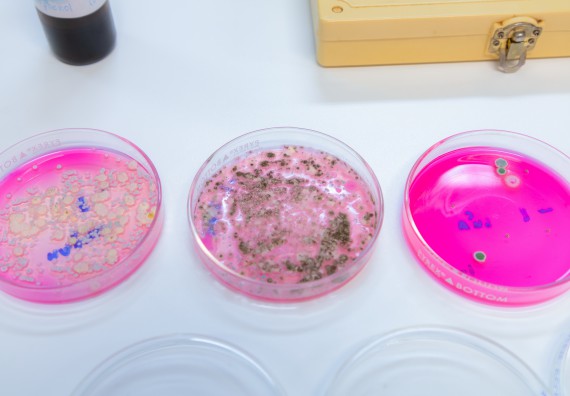
ภาพกิจกรรม  คณะวิทยาศาสตร์และเทคโนโลยี มหาวิทยาลัยราชภัฏกำแพงเพชร ร่วมกับโรงเรียนกำแพงเพชรพิทยาคม จัดกิจกรรมค่ายวิทยาศาสตร์นักเรียนห้องเรียนพิเศษวิทยาศาสตร์
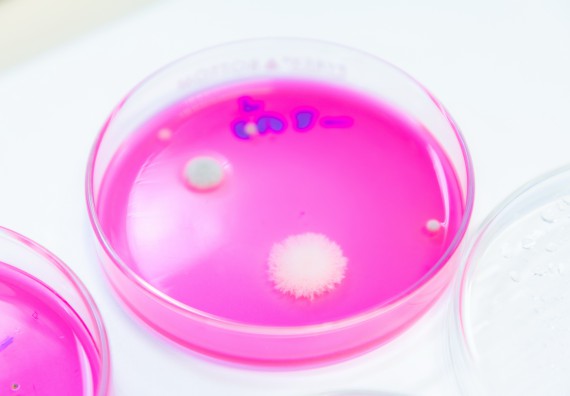
ภาพกิจกรรม  คณะวิทยาศาสตร์และเทคโนโลยี มหาวิทยาลัยราชภัฏกำแพงเพชร ร่วมกับโรงเรียนกำแพงเพชรพิทยาคม จัดกิจกรรมค่ายวิทยาศาสตร์นักเรียนห้องเรียนพิเศษวิทยาศาสตร์
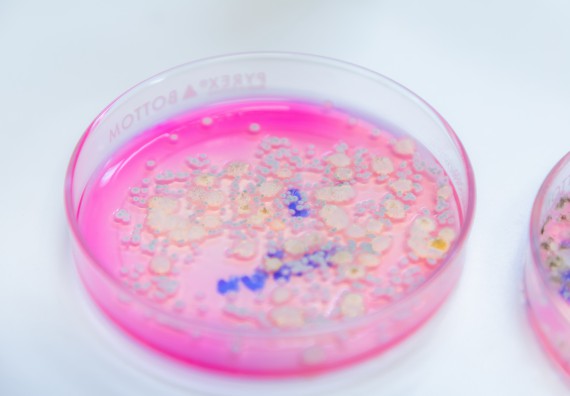
ภาพกิจกรรม  คณะวิทยาศาสตร์และเทคโนโลยี มหาวิทยาลัยราชภัฏกำแพงเพชร ร่วมกับโรงเรียนกำแพงเพชรพิทยาคม จัดกิจกรรมค่ายวิทยาศาสตร์นักเรียนห้องเรียนพิเศษวิทยาศาสตร์
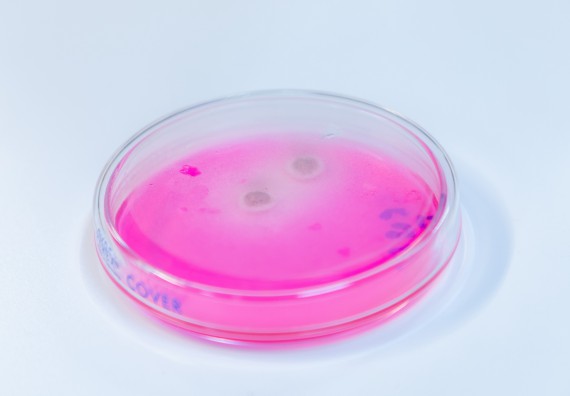
ภาพกิจกรรม  คณะวิทยาศาสตร์และเทคโนโลยี มหาวิทยาลัยราชภัฏกำแพงเพชร ร่วมกับโรงเรียนกำแพงเพชรพิทยาคม จัดกิจกรรมค่ายวิทยาศาสตร์นักเรียนห้องเรียนพิเศษวิทยาศาสตร์
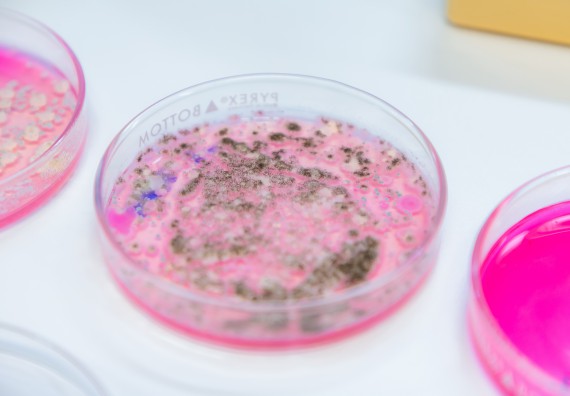
ภาพกิจกรรม  คณะวิทยาศาสตร์และเทคโนโลยี มหาวิทยาลัยราชภัฏกำแพงเพชร ร่วมกับโรงเรียนกำแพงเพชรพิทยาคม จัดกิจกรรมค่ายวิทยาศาสตร์นักเรียนห้องเรียนพิเศษวิทยาศาสตร์

คณะวิทยาศาสตร์และเทคโนโลยี มหาวิทยาลัยราชภัฏกำแพงเพชร ร่วมกับโรงเรียนกำแพงเพชรพิทยาคม จัดกิจกรรมค่ายวิทยาศาสตร์นักเรียนห้องเรียนพิเศษวิทยาศาสตร์ ให้กับนักเรียนระดับชั้นมัธยมศึกษาปีที่ 2 จำนวน 101 คน โดยมีวัตถุประสงค์เพื่อให้นักเรียนห้องเรียนพิเศษวิทยาศาสตร์ ระดับชั้นมัธยมศึกษาปีที่ 2 ตระหนักถึงการเรียนรู้ ตลอดจนนำความรู้ ทักษะด้านวิทยาศาสตร์ที่ได้รับมาพัฒนาองค์ความรู้ให้เกิดประโยชน์ต่อตนเองและประเทศชาติในอนาคต ในวันเสาร์ที่ 6 กันยายน พ.ศ. 2568 เวลา 08.30-15.00 น. ณ อาคารเรียนและปฏิบัติการทางวิทยาศาสตร์ คณะวิทยาศาสตร์และเทคโนโลยี มหาวิทยาลัยราชภัฏกำแพงเพชร "กิจกรรมหลักสูตรประกอบด้วย สาขาวิชานวัตกรรมและธุรกิจอาหาร วิทยาศาสตร์ในห้องครัว สาขาวิชาเคมี การแยกสารละลาย สาขาวิชาชีววิทยา ระบบอวัยวะ"

งานพัฒนาสารสนเทศและงานประชาสัมพันธ์